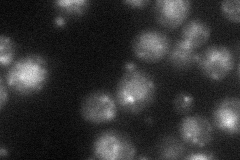
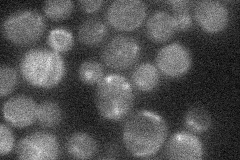

View description
Meiosis-specific prospore membrane protein; required to produce bending force necessary for proper assembly of the prospore membrane during sporulation
Localization:
Intensity:
Fold change:
Significance:
-
C’ GFP library in SD

below threshold13.78 -
N' NOP1pr-GFP in SD
punctate,vacuole33.5695 -
N' TEF2pr-mCherry in SD

cell periphery,punctate,vacuole50.469 -
N' NATIVEpr-GFP in SD
below threshold21.0197 -
N' TEF2pr-VC and Cyto-VN in SD

below threshold23.9459 -
C’ GFP library in SD+DTT

cytosol15.661.13No -
C’ GFP library in SD+H2O2

cytosol18.211.32No -
C’ GFP library in Starvation Media

cytosol21.751.57No -
C’ GFP library on the background of Pup2-DaMP

below threshold -
C’ GFP library on the background of CCT mutant

below threshold17.02231.23475No
